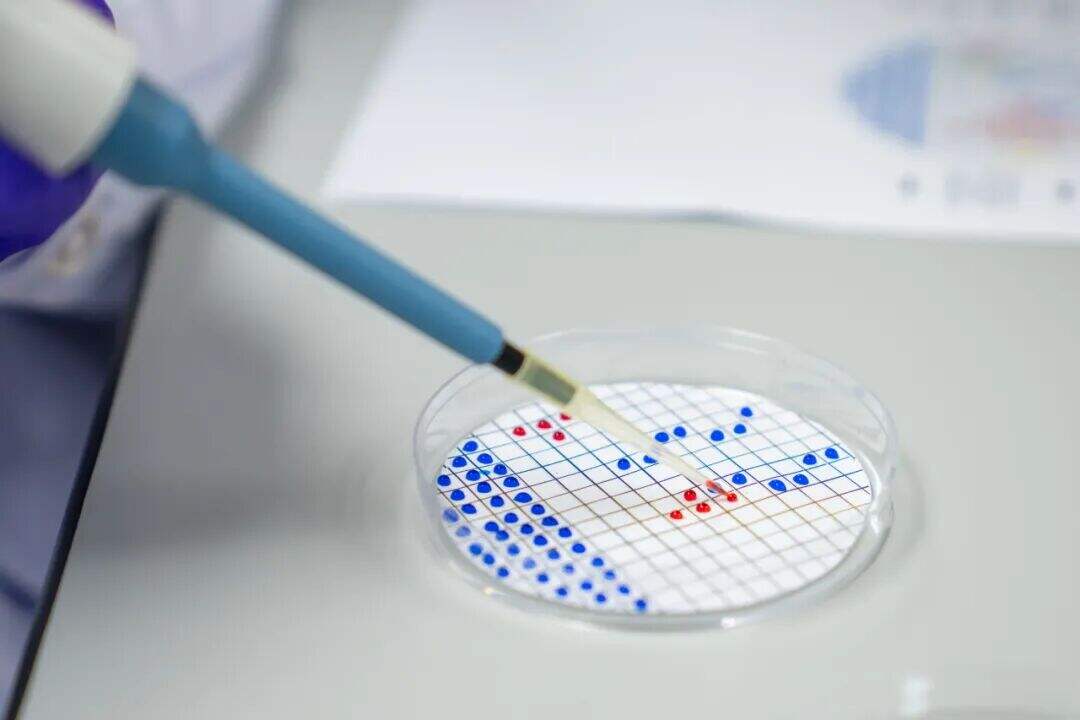
图片

从实验室到海洋:惠灵顿iGEM队的“藤壶克星”征途
一群平均年龄不到17岁的学生,能创造出什么?
上海惠灵顿的12名学生,用10个月的时间,给出了一个令人惊喜的答案:他们组成了学校第一支iGEM团队,将目光投向广袤海洋中一个微小却代价高昂的问题——藤壶附着,并尝试用合成生物学的方法,为这个世界级难题提供一个环保、可持续的解决方案。
他们的项目名叫“Barnacure”(藤壶克星),一个充满少年志气的名字背后,是一场融合了好奇心、创造力与科学严谨性的旅程。

iGEM(国际基因工程机器大赛)是由麻省理工学院发起的一项全球性基因工程竞赛。该赛事始于2003年,现已发展成为合成生物学领域最具影响力的学生科技活动之一。每年吸引来自全球40多个国家和地区的超过300支队伍参赛,涵盖本科、研究生及高中组别。


上海惠灵顿Barnacure团队成员与指导教师
当学科兴趣照进现实
故事始于一个简单的疑问:“藤壶为什么能粘得那么牢?”
这个在海岸边随处可见的现象,却牵动着全球航运业每年数百亿美元的神经。藤壶等生物在船体表面的附着,会增加航行阻力,导致燃油消耗激增、温室气体排放增多,而传统采用重金属毒素的防污涂料,又对海洋生态造成持久伤害。



“通过iGEM竞赛,我希望将好奇心、创造力与科学严谨性相结合,为团队乃至更广阔的社群作出有意义的贡献。”队长Yixuan分享道。正是这份源自学科深处的热爱,驱动着团队从零开始,直面挑战。
他们从文献中找到了关键——藤壶通过一种名为cp19k的蛋白实现强力黏附。那么,能否找到一种酶,像“生物剪刀”一样精准降解这种蛋白,从而从根源上阻止藤壶附着,又不伤害其他海洋生物?
这个大胆的设想,成为了“Barnacure”项目的起点。
十个月,从“为什么”到“怎么做”
iGEM竞赛的魅力,在于它要求团队完成一个从构思、设计、实验到社会实践的完整闭环。对于这群首次参赛的学生而言,每一步都是挑战,也都是成长。
在实验组成员Asger看来,在实验室的时光既像“用基因乐高搭建未知模型”一样有趣,也充满了反复试错的挫折。

团队在校内从零搭建起完整的生物技术实验室,逐步完成了cp19k 基因的 GC 含量优化,成功转化并表达 Balcp19k 蛋白,并模拟海洋环境,测试不同条件下酶的降解效果。
不止于竞赛,更关乎责任与成长
十个月的征程,让这个团队收获的远不止于一个项目方案,更是视野上的开拓。“加入iGEM这项享有盛誉的合成生物学竞赛,不仅能打磨我的实验技能,还能让我接触到其他精彩的创新提案。” 干实验室负责人David对此深有感触。通过赛事平台,他们看到了全球同龄人如何运用生物学思维解决各类现实问题,这进一步坚定了他们的信念。
项目负责老师、中学生物及科学学科主任Thomas Edwards对此评价道:“我们鼓励学生探索个人热情所在,并为他们提供将想法转化为实际行动的支持体系。iGEM团队正是这一教育哲学的完美体现。他们展现出的科研素养、解决问题的韧性、社会责任感以及团队协作精神,正是面向未来的教育所希望培养的核心品质。”



从惠灵顿的实验室出发,iGEM队员们的思考与行动,已然触及了海洋生态保护与绿色航运的宏大命题。他们的旅程,不仅关乎科学,更关乎教育最动人的本质:点燃兴趣,赋予能力,然后放手让年轻的心灵,去创造他们相信的美好未来。
与iGEM团队面对面

Contact Admissions
联系我们
Early Years
幼儿部
Primary
小学部
Secondary
中学部
+(86-21) 5185-3885
+(86-21) 5185-3864
EYC/幼儿部: +(86-21) 3158 0008-7523
admissions.shanghai@wellingtoncollege.cn
相关资讯








